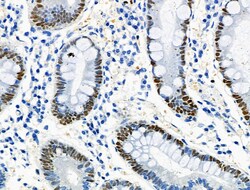
Invitrogen Phospho-MCM2 (Ser27) Polyclonal Antibody 100 &mu;L; Unconjugated:Antibodies,

missing translation for 'onlineSavingsMsg'
Learn More
Learn More
Invitrogen™ Phospho-MCM2 (Ser27) Polyclonal Antibody


Rabbit Polyclonal Antibody
Brand: Invitrogen™ PA5106186
This item is not returnable.
View return policy
Description
Antibody detects endogenous levels of MCM2 only when phosphorylated at Ser27.
MCM2 (Mini chromosome maintenance protein 2) is involved in regulating DNA replication. MCM2 (also called CDCL1, mitotin and BM28), is a human nuclear protein that is crucial in the cell cycle, being involved in the onset of DNA replication and cell division. It is similar to members of the family of early S-phase proteins. MCM2 has been mapped to 3q21. From its localization, CDCL1 became a candidate for an oncogene affected by chromosomal breaks in acute myeloid leukemia (AML).
Specifications
| Phospho-MCM2 (Ser27) | |
| Polyclonal | |
| Unconjugated | |
| MCM2 | |
| AA959861; AW476101; BM28; CCNL1; cdc19; CDCL1; cell devision cycle-like 1; cyclin-like 1; D3S3194; DFNA70; DNA replication licensing factor MCM2; Kiaa0030; MCM DNA helicase complex subunit MCM2; Mcm2; Mcmd2; MGC10606; mini chromosome maintenance deficient 2; minichromosome maintenance complex component 2; minichromosome maintenance deficient 2 (mitotin); minichromosome maintenance deficient 2 mitotin; minichromosome maintenance deficient 2 mitotin (S. cerevisiae); Minichromosome maintenance protein 2; Minichromosome maintenance protein 2 homolog; MITOTIN; mKIAA0030; Nuclear protein BM28; YBL023C; YBL0438 | |
| Rabbit | |
| Sequential Chromatography | |
| RUO | |
| 17216, 312538, 4171 | |
| -20°C | |
| Liquid |
| Immunohistochemistry (Paraffin), Western Blot | |
| 1 mg/mL | |
| PBS with 50% glycerol and 0.02% sodium azide; pH 7.4 | |
| P49736, P97310 | |
| MCM2 | |
| A synthesized peptide derived from human MCM2(Accession P49736), corresponding to amino acid residues around phosphorylated Ser27. | |
| 100 μL | |
| Primary | |
| Human, Mouse, Rat | |
| Antibody | |
| IgG |
Product Content Correction
Your input is important to us. Please complete this form to provide feedback related to the content on this product.
Product Title
Spot an opportunity for improvement?Share a Content Correction